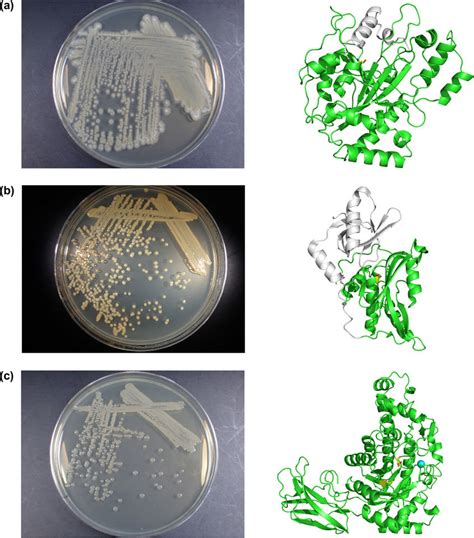

Unveiling Streptomyces Mobaraensis Transglutaminase
Unveiling Streptomyces Mobaraensis Transglutaminase: A Deep Dive
Hey guys! Let’s dive deep into the fascinating world of Streptomyces mobaraensis transglutaminase ! This enzyme is a real game-changer in various industries. We’re talking about a biological marvel that’s got some seriously cool tricks up its sleeve. From food science to biomedicine, it’s making waves, and today, we’re going to break down everything you need to know. We will examine what makes this particular transglutaminase so special. We will consider the properties, applications, and potential of this amazing enzyme. Prepare to be amazed by the versatility of Streptomyces mobaraensis transglutaminase. Let’s get started!
Table of Contents
What Exactly is Transglutaminase and Why Should You Care?
Alright, so what is transglutaminase ? In simple terms, it’s an enzyme that acts like a molecular glue, catalyzing the formation of covalent bonds between proteins. These bonds create cross-links, altering the structure and properties of proteins. The result? Changes in texture, stability, and functionality! Streptomyces mobaraensis transglutaminase is a microbial transglutaminase (mTG), derived from the bacterium Streptomyces mobaraensis . Compared to its animal-derived counterparts, mTG offers some distinct advantages. It is produced through fermentation, which offers scalability, consistency, and avoids ethical concerns associated with animal sources. Also, it’s a super versatile enzyme. It can modify a wide range of proteins. Transglutaminase is important because it can dramatically improve the qualities of products.
One of the coolest things about transglutaminase is its ability to create new food products, enhance existing ones, and even improve the performance of non-food applications. Whether you’re a food scientist, a biotechnologist, or just a curious individual, understanding this enzyme is crucial. It’s like a secret ingredient. It can unlock a whole new world of possibilities. Think about it: improved texture in processed meats, enhanced elasticity in baked goods, and even stronger adhesives in industrial applications. Pretty neat, right? The potential applications are vast, making this enzyme a hot topic in many fields. Let’s delve into what makes Streptomyces mobaraensis transglutaminase so unique.
The Unique Properties of Streptomyces Mobaraensis Transglutaminase
Now, let’s get into the nitty-gritty of Streptomyces mobaraensis transglutaminase. What makes it stand out from the crowd? This particular enzyme boasts some unique characteristics that set it apart. First off, its source, Streptomyces mobaraensis , is a well-studied bacterium. This has resulted in a deeper understanding of the enzyme’s structure and function. The enzyme’s high activity at various pH levels and temperatures is a key factor. This makes it incredibly useful in a wide array of applications. This robust nature is a huge benefit when it comes to industrial processes. Unlike some other enzymes that might be finicky about their environment, this one is built to last. It is stable and functional under many conditions. The stability means it’s less likely to denature. This ensures consistent performance, even under less-than-ideal conditions. And that, my friends, is a significant advantage. It simplifies production processes and boosts the reliability of the end product. The enzyme’s substrate specificity also plays a significant role in its versatility. It can modify a wide variety of proteins. It means it can be used to improve the texture, stability, and other properties of different products. Plus, its ability to catalyze reactions efficiently and with high selectivity makes it a cost-effective solution. Let’s not forget about its compatibility with other ingredients. Streptomyces mobaraensis transglutaminase is often compatible with a broad range of food additives and processing methods. This allows for greater flexibility in product development. It is something other enzymes struggle with. These unique properties make it an invaluable tool. It is something that scientists and manufacturers worldwide have come to depend on.
Applications Across Industries: Where Streptomyces Mobaraensis Transglutaminase Shines
Okay, so where does this enzyme actually get used? Let’s take a look at the various industries where Streptomyces mobaraensis transglutaminase is making a name for itself. In the food industry, this enzyme is a true star. It’s used in meat processing to improve texture and binding. Think about how it can enhance the quality of processed meats, sausages, and other products by creating firmer textures and reducing cooking loss. It can also be found in dairy products, where it enhances the texture and stability of yogurt and cheese.
But that’s not all! The enzyme plays a role in the creation of gluten-free products. This helps improve the texture of gluten-free baked goods. It provides that perfect rise and chewy texture that’s often missing. Moving beyond food, transglutaminase finds applications in other fields. In the cosmetic industry, it’s used in skincare products. It improves the properties of collagen-based products. It can also be found in biomedical applications, such as tissue engineering and drug delivery. It’s helping to develop new treatments and therapies. It works by creating stronger, more stable materials. These materials can be used to construct scaffolds for cell growth. It can also be used to deliver drugs.
In the textile industry, Streptomyces mobaraensis transglutaminase can modify protein-based fibers. This results in stronger and more durable fabrics. The versatility of this enzyme is truly astonishing. Its ability to work in so many different contexts underscores its importance. This is why researchers and businesses are always finding new ways to use it. The applications are constantly expanding. It is a testament to its effectiveness and adaptability. It’s pretty cool, right?
The Benefits of Using Streptomyces Mobaraensis Transglutaminase
Alright, let’s talk about the key benefits. Why should you consider using Streptomyces mobaraensis transglutaminase? First off, there’s the improved product quality. Whether it’s better texture, increased stability, or enhanced functionality, this enzyme can elevate the overall quality of your products. It’s a game-changer when it comes to consumer satisfaction. Using transglutaminase is a win-win situation. Consumers get better products, and businesses can improve their brand reputation. Then there’s the enhanced processing efficiency. The enzyme’s stability and activity under various conditions can streamline production processes. It reduces waste, and it increases efficiency. This translates into cost savings. This is critical in a competitive market. It helps businesses optimize their operations. Another major benefit is the ability to create innovative products. The unique properties of this enzyme allow for the development of new and improved formulations. It opens up opportunities to cater to the changing needs and preferences of consumers. Consider its use in developing gluten-free products. This also includes creating meat alternatives. The enzyme can also be used to create products that meet specific dietary requirements. It provides a huge advantage in today’s market. Moreover, the use of Streptomyces mobaraensis transglutaminase aligns with consumer demands for natural and sustainable ingredients. It is a microbial enzyme, which is produced through fermentation. This makes it an attractive alternative to chemically-modified ingredients. This is a big plus for businesses aiming to attract eco-conscious consumers. The benefits are numerous, but the potential is even greater.
Challenges and Considerations
Of course, no technology is without its challenges. Let’s take a look at some of the things you need to consider when working with Streptomyces mobaraensis transglutaminase. One key consideration is the potential for allergenicity. While the enzyme itself is generally safe, it’s important to be aware of the source and any potential allergens. This is especially relevant in food applications. Proper labeling and awareness of potential sensitivities are crucial. Another challenge is ensuring the optimal use of the enzyme. The activity and efficiency of transglutaminase depend on factors such as pH, temperature, and substrate concentration. Careful optimization of these parameters is important to maximize the benefits. Also, ensuring the long-term stability and storage of the enzyme is critical. Maintaining its activity over time can be a challenge. It’s important to follow storage guidelines and handle the enzyme properly to prevent degradation. Furthermore, regulatory considerations vary. Different countries have different regulations. This can affect the use of transglutaminase in various products. Staying up-to-date with these regulations is necessary. This will ensure compliance and avoid any potential issues. Finally, there’s the cost. While Streptomyces mobaraensis transglutaminase offers many benefits, the cost of the enzyme and the overall processing may be a concern. However, the benefits often outweigh the costs. The potential for improved product quality, efficiency, and innovation can result in long-term savings. Despite these challenges, the advantages of using Streptomyces mobaraensis transglutaminase are quite impressive. Careful planning, optimization, and adherence to regulations are the key to successfully using this powerful enzyme.
Future Trends and Research Directions
What does the future hold for Streptomyces mobaraensis transglutaminase? The enzyme is still in the research phase. The developments are rapid. There are several exciting trends and research directions to look out for. One of the main focuses is on improving the enzyme’s performance. Scientists are working on ways to enhance its activity, stability, and substrate specificity. This will expand the range of applications. Another key area is the development of new applications. Researchers are exploring novel uses in the food, cosmetic, and biomedical industries. This includes creating new food products with unique textures and functionalities, as well as developing advanced medical treatments. One area of great interest is the creation of new and improved methods. This is to produce and purify transglutaminase more efficiently and cost-effectively. This will make it more accessible to a wider range of industries and applications. The combination of transglutaminase with other ingredients and processing techniques. This will allow for synergistic effects and the creation of products with enhanced properties. Another emerging trend is the use of bioinformatics and genetic engineering. This is to further understand the enzyme’s structure and function. It also allows for the development of customized transglutaminases with specific properties for specific applications. As the field of biotechnology continues to advance, we can expect to see even more innovative uses of Streptomyces mobaraensis transglutaminase. The potential is enormous, and the future looks bright for this amazing enzyme.
Conclusion: The Incredible Impact of Streptomyces Mobaraensis Transglutaminase
So, what’s the bottom line? Streptomyces mobaraensis transglutaminase is a powerful and versatile enzyme. It offers a wide range of benefits across various industries. From improving food quality to creating innovative biomedical applications, its impact is undeniable. The unique properties of this enzyme, combined with its ability to modify proteins, make it an invaluable tool for scientists, manufacturers, and consumers. As research continues and new applications are developed, the potential of Streptomyces mobaraensis transglutaminase will only grow. This will create exciting possibilities for innovation and progress. This enzyme is changing the way we think about food, cosmetics, and medicine. So, the next time you encounter a product with an improved texture, enhanced stability, or unique functionality, remember the power of Streptomyces mobaraensis transglutaminase. It’s a key player in the exciting world of biotechnology. Thanks for joining me on this journey! Until next time, keep exploring the wonders of science!